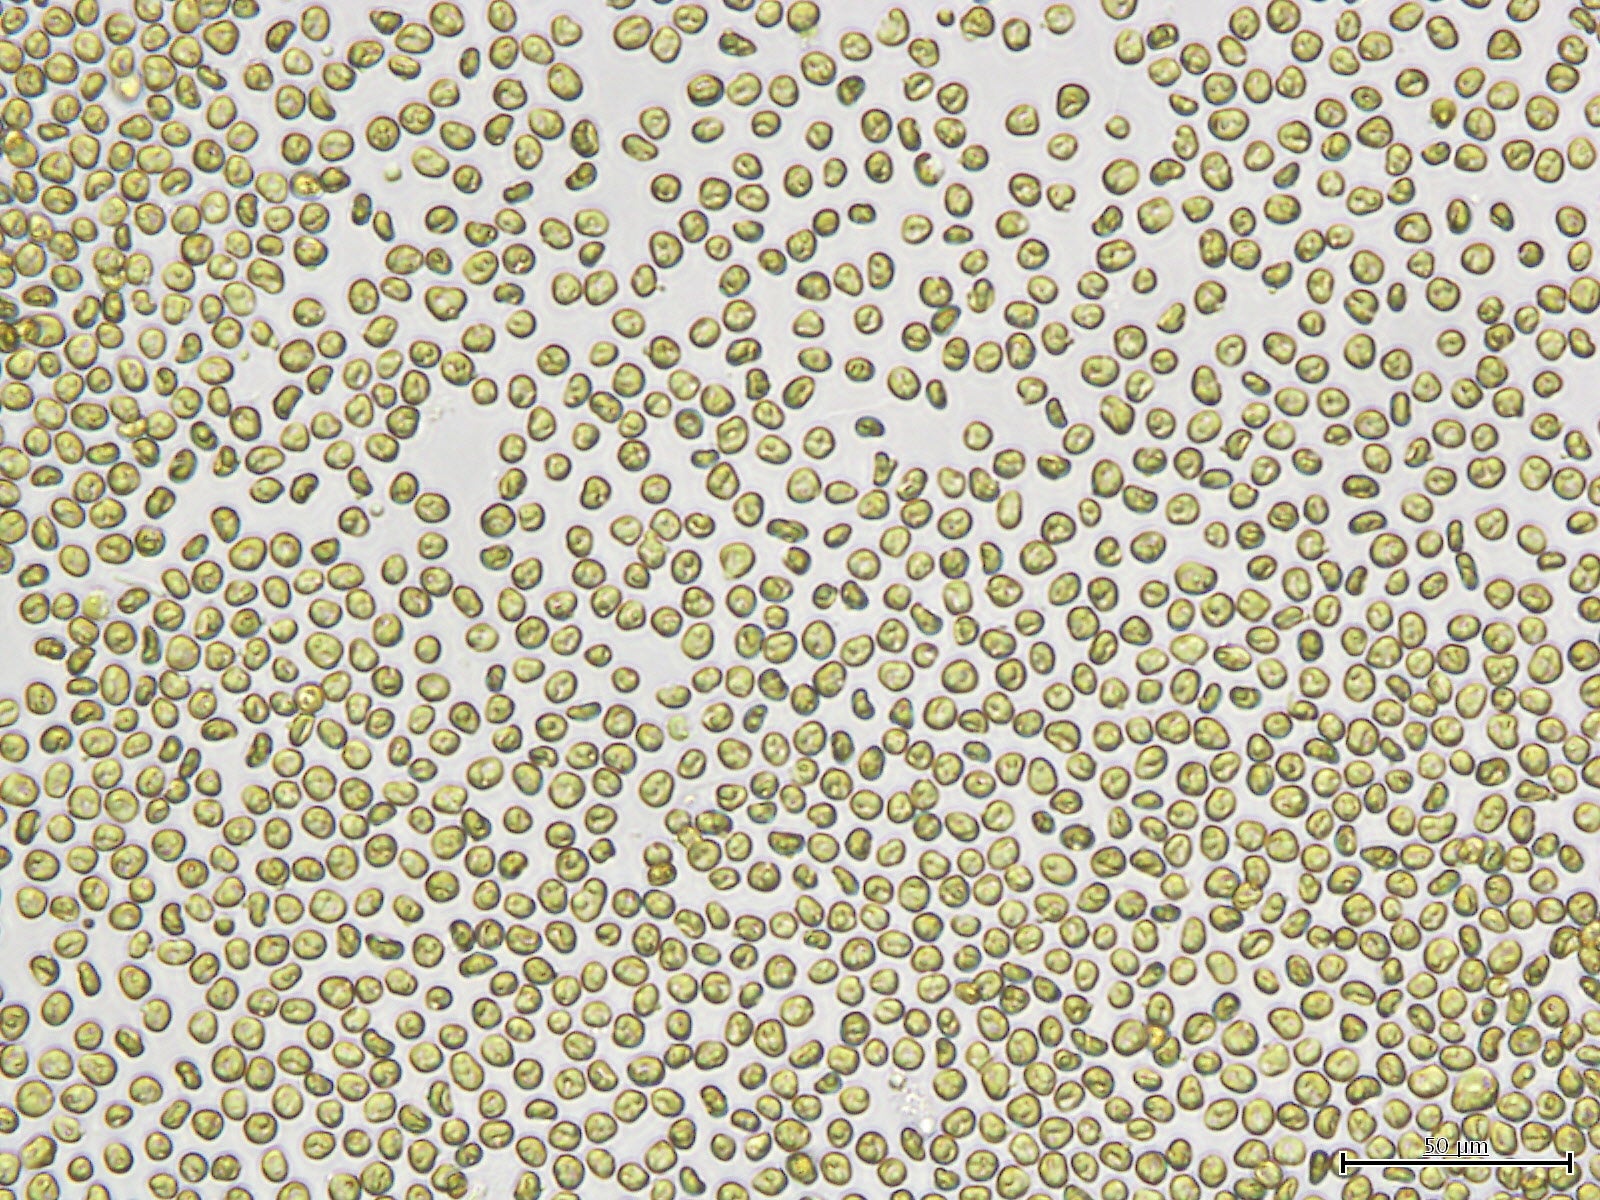
微細藻類Pavlova（パブロバ）

【オーピーバイオファクトリー×ロート製薬】藻類共同研究・アライアンス拠点「AMU LABORATORY」始動 微細藻類の新たな価値創造、事業化へ
-バイオテクノロジーによりウェルビーイングな明日の世界を創る-
オーピーバイオファクトリー株式会社(本社:沖縄県うるま市、代表取締役 金本昭彦、以下「OPBio」)は、「微細藻類」の高付加価値原料のさらなる研究開発および商品化・事業化を目指すべく、2022年2月24日にロート製薬株式会社(本社:大阪市、社長:杉本雅史、以下 ロート製薬)と共同で沖縄県うるま市にて藻類研究拠点「AMU LABORATORY」を設立し、協業を開始します。そして、本協業の成果をヘルスケア領域における新しい価値創造へと繋げるべく尽力して参ります。
■背景
近年、最新のバイオテクノロジーと生物資源を用いて、地球規模の課題解決と経済発展の共存を目指す「バイオエコノミー」という考え方が国際的に提唱され、食、健康、医療等、環境など様々な分野における技術革新により2030年までに200兆円の巨大市場へと成長が見込まれています。※1また、政府により2050年にカーボンニュートラルを目指すことが宣言されたことを受け、環境課題解決や地域のエコシステム構築など、多様な可能性を秘めたエシカルでサステナブルな素材として微細藻類は大きな注目を集めています。
フォトバイオリアクターの登場により、これまで培養困難とされてきた有用微細藻類の大量培養、商業利用が可能となり、各分野における微細藻類利用が活発化してきています。
ロート製薬とは2021年よりパブロバを利用した商品開発をはじめ、保有する1,000株以上の微細藻類コレクションを用いた研究開発を共同で実施して参りました。
※1最新バイオテクノロジーと生物資源を用いて、地球規模の課題解決と経済発展の共存を目指す考え方
OECD, “The Bioeconomy to 2030: designing a policy agenda”、経済産業省, https://www.meti.go.jp/press/2020/02/20210202001/20210202001-1.pdf
■藻類研究・アライアンスの拠点 「AMU LABORATORY」
微細藻類の培養検討から製品応用に至るR&D機能に加え、研究開発アライアンス拠点として事業化を推進する為、OPBio、ロート製薬および株式会社ロート・F・沖縄(沖縄県うるま市、社長:中原剣)と共同で「AMU LABORATORY」を設立いたします。
ロート製薬とOPBioにおけるこれまでの連携を通じて、微細藻類Pavlova(パブロバ)において新たな機能性を見出し、その研究成果を反映したサプリメント「Pavlova MCT+、パブロバエムシーティープラス」※2を2022年2月24日にリニューアル発売開始いたします。
また、スキンケア領域においてパブロバにはエイジングケア効果も期待され、現在、ロート製薬と化粧品原料の開発を進めており、2022年中の製品応用を目指しております。※2「Pavlova MCT+」:https://pavlova.jp/
当社は沖縄の海洋生物資源が持つ能力を活用して人々の健康向上に貢献する事をミッションとして、海洋調査会社からスピンアウトする形で2006年に設立されました。海洋調査で培った技術を使って生物資源を収集し、それらを利用して、経験豊富なプロフェッショナルチームが、医薬品、食品、化粧品、化成品、環境・エネルギー等の多様な領域において有用成分および機能性の探索サービスを提供しています。今後も微細藻類をはじめとした生物資源が持つ能力を開放し、社会実装していく取り組みを社内外のパートナーとともに推進して参ります。
■研究拠点「AMU LABORATORY」概要
設立年月日:2022年2月24日
所在地:沖縄県うるま市州崎 (OPBioラボ内)
連絡先:info.amulab@rohto.co.jp (事業連携・研究等に関するお問合せ)
*「AMU」は最先端バイオテクノロジーを使って未来を編集していく、未来をamuseしていく、という想いが込められています。
【会社概要】
会社名:オーピーバイオファクトリー株式会社
代表取締役:金本昭彦
所在地:沖縄県うるま市字州崎5番8
・OPBio factory 公式WEBサイト:http://www.opbio.com/
・OPBio factory 公式facebook:https://www.facebook.com/opbio
・Pavlova 公式ブランドサイト:https://pavlova.jp/
・Pavlova 公式facebook:https://www.facebook.com/pavlova.okinawa
・Pavlova 公式instagram:https://www.instagram.com/pavlova_okinawa_official/
近年、最新のバイオテクノロジーと生物資源を用いて、地球規模の課題解決と経済発展の共存を目指す「バイオエコノミー」という考え方が国際的に提唱され、食、健康、医療等、環境など様々な分野における技術革新により2030年までに200兆円の巨大市場へと成長が見込まれています。※1また、政府により2050年にカーボンニュートラルを目指すことが宣言されたことを受け、環境課題解決や地域のエコシステム構築など、多様な可能性を秘めたエシカルでサステナブルな素材として微細藻類は大きな注目を集めています。
 国内最大規模のガラスチューブ型フォトバイオリアクター (沖縄県うるま市OPBioラボ併設)
国内最大規模のガラスチューブ型フォトバイオリアクター (沖縄県うるま市OPBioラボ併設)
当社では約10年前から微細藻類の可能性に着目し、沖縄沿岸域より約1,000株の微細藻類株を収集し、医薬、食品、化粧品、化成品、燃料など様々な領域における研究開発を実施して参りました。また、沖縄県うるま市において国内最大規模のガラスチューブ型のフォトバイオリアクター(微細藻類野外培養設備)を設置し、微細藻類の社会実装に関する開発に取り組んで参りました。その成果の一例として微細藻類の一種パブロバを用いたサプリメントを開発し、2021年より販売開始しています。
フォトバイオリアクターの登場により、これまで培養困難とされてきた有用微細藻類の大量培養、商業利用が可能となり、各分野における微細藻類利用が活発化してきています。
ロート製薬とは2021年よりパブロバを利用した商品開発をはじめ、保有する1,000株以上の微細藻類コレクションを用いた研究開発を共同で実施して参りました。
※1最新バイオテクノロジーと生物資源を用いて、地球規模の課題解決と経済発展の共存を目指す考え方
OECD, “The Bioeconomy to 2030: designing a policy agenda”、経済産業省, https://www.meti.go.jp/press/2020/02/20210202001/20210202001-1.pdf
■藻類研究・アライアンスの拠点 「AMU LABORATORY」
微細藻類の培養検討から製品応用に至るR&D機能に加え、研究開発アライアンス拠点として事業化を推進する為、OPBio、ロート製薬および株式会社ロート・F・沖縄(沖縄県うるま市、社長:中原剣)と共同で「AMU LABORATORY」を設立いたします。

ロート製薬とOPBioにおけるこれまでの連携を通じて、微細藻類Pavlova(パブロバ)において新たな機能性を見出し、その研究成果を反映したサプリメント「Pavlova MCT+、パブロバエムシーティープラス」※2を2022年2月24日にリニューアル発売開始いたします。
また、スキンケア領域においてパブロバにはエイジングケア効果も期待され、現在、ロート製薬と化粧品原料の開発を進めており、2022年中の製品応用を目指しております。※2「Pavlova MCT+」:https://pavlova.jp/
微細藻類Pavlova(パブロバ)
微細藻類Pavlova(パブロバ)
 Pavlova MCT+ 1ヶ月分パウチ
Pavlova MCT+ 1ヶ月分パウチ
 Pavlova MCT+ 5 日間トライアルセット
Pavlova MCT+ 5 日間トライアルセット
当社は沖縄の海洋生物資源が持つ能力を活用して人々の健康向上に貢献する事をミッションとして、海洋調査会社からスピンアウトする形で2006年に設立されました。海洋調査で培った技術を使って生物資源を収集し、それらを利用して、経験豊富なプロフェッショナルチームが、医薬品、食品、化粧品、化成品、環境・エネルギー等の多様な領域において有用成分および機能性の探索サービスを提供しています。今後も微細藻類をはじめとした生物資源が持つ能力を開放し、社会実装していく取り組みを社内外のパートナーとともに推進して参ります。
■研究拠点「AMU LABORATORY」概要
設立年月日:2022年2月24日
所在地:沖縄県うるま市州崎 (OPBioラボ内)
連絡先:info.amulab@rohto.co.jp (事業連携・研究等に関するお問合せ)
*「AMU」は最先端バイオテクノロジーを使って未来を編集していく、未来をamuseしていく、という想いが込められています。
【会社概要】
会社名:オーピーバイオファクトリー株式会社
代表取締役:金本昭彦
所在地:沖縄県うるま市字州崎5番8
・OPBio factory 公式WEBサイト:http://www.opbio.com/
・OPBio factory 公式facebook:https://www.facebook.com/opbio
・Pavlova 公式ブランドサイト:https://pavlova.jp/
・Pavlova 公式facebook:https://www.facebook.com/pavlova.okinawa
・Pavlova 公式instagram:https://www.instagram.com/pavlova_okinawa_official/
このプレスリリースには、メディア関係者向けの情報があります
メディアユーザーログイン既に登録済みの方はこちら
メディアユーザー登録を行うと、企業担当者の連絡先や、イベント・記者会見の情報など様々な特記情報を閲覧できます。※内容はプレスリリースにより異なります。
すべての画像